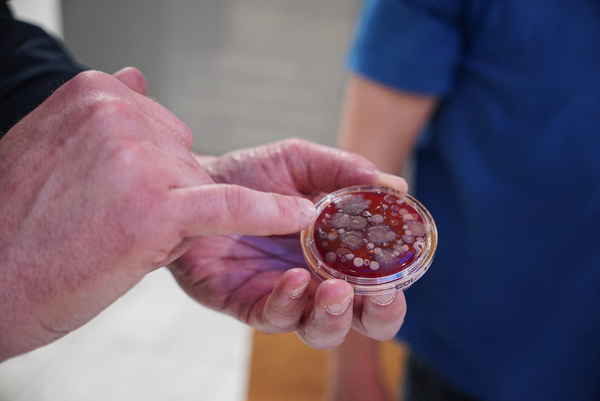

Unsere Hände sind ständig in Bewegung – und kommen dabei immer wieder mit für uns unsichtbaren Keimen in Berührung. Darauf soll jährlich der Internationale Tag der Händehygiene aufmerksam machen, den das Klinikum Mutterhaus in Trier zum Anlass nahm, mit einer Aktionswoche auf das Thema aufmerksam zu machen. An verschiedenen Stationen konnten Mitarbeitende, Patienten und Besucher mehr über die Wichtigkeit sauberer Hände für ein gesundes Leben erfahren.
Christian Mertes, Facharzt für Hygiene und Umweltmedizin am Klinikum Mutterhaus, beantwortet im Interview Fragen rund um Händehygiene im Alltag, populäre Irrtümer und ob die Pandemie dabei einen spürbaren Wandel bewirkt hat.
Herr Mertes, wie oft haben Sie sich heute schon die Hände gewaschen?
Christian Mertes: Wahrscheinlich öfter, als mir bewusst ist – mindestens nach dem Toilettengang, vor dem Essen und nach dem Kontakt mit potenziell verunreinigten Oberflächen. Im Alltag passiert das oft ganz automatisch.
Welche Rolle spielt das Händewaschen mit Wasser und Seife in Sachen Händehygiene? Und was sollte man beachten, damit es sinnvoll und vor allem wirksam ist?
Christian Mertes: Händewaschen ist die klassische Methode zur Entfernung von sichtbarem Schmutz und vielen Keimen. Es ist vor allem im Alltag sinnvoll – etwa nach dem Toilettengang, beim Kochen oder nach dem Kontakt mit Tieren.
Desinfektionsmittel wirken chemisch und töten zuverlässig Bakterien, viele Viren und Pilze – deshalb sind sie im medizinischen Bereich unverzichtbar, im Alltag aber meist nur ergänzend nötig.
Wichtig: Desinfektionsmittel wirken nur auf sauberen und trockenen Händen zuverlässig. Sind die Hände feucht oder verschmutzt, sollte man sie erst waschen, gründlich abtrocknen – und dann desinfizieren. Feuchtigkeit kann die Wirkung deutlich abschwächen.
Wir alle wurden in den vergangenen Jahren ja unfreiwillig täglich mit dem Thema Infektionsschutz konfrontiert. Haben Sie den Eindruck, dass die Corona-Pandemie die Menschen nachhaltig für das Thema Händehygiene sensibilisiert hat?
Christian Mertes: Ja, das Bewusstsein für Infektionsschutz ist spürbar gewachsen. Viele Menschen haben erstmals wirklich verstanden, wie schnell sich Krankheitserreger verbreiten – und wie wirksam einfache Maßnahmen wie Händewaschen oder Desinfektion sein können.
Gleichzeitig erleben wir aber auch eine gewisse Pandemiemüdigkeit. Viele möchten das Thema hinter sich lassen – verständlich. Genau hier setzen wir an: Wir greifen das Thema neu, pragmatisch und ohne erhobenen Zeigefinger auf.
Gerade im Gesundheitswesen ist das entscheidend: Bis zu 90 % aller Infektionen in Zusammenhang mit medizinischen Behandlungen wären durch konsequente Händehygiene vermeidbar. Eine einfache Maßnahme – mit großer Wirkung, für Patienten und Mitarbeitende.
Auch heute stehen an vielen Stellen im öffentlichen Raum noch Desinfektionsspender. Ist Händedesinfektion im Alltag überhaupt sinnvoll – oder ist es mit gründlichem Händewaschen nicht schon getan?
Christian Mertes: In den meisten Alltagssituationen reicht gründliches Händewaschen völlig aus. Händedesinfektion ist dann sinnvoll, wenn keine Waschgelegenheit vorhanden ist – etwa unterwegs, nach dem Berühren von Haltegriffen oder beim Besuch im Krankenhaus. Auch bei Kontakt mit Erkrankten oder in der Grippezeit kann sie helfen.
Auch außerhalb von pandemischen Zeiten ist das Unterbrechen von Infektionsketten sehr wichtig. Wie kann man im Alltag aktiv dazu beitragen?
Christian Mertes: Krankheitserreger begegnen uns überall, etwa auf Türklinken oder Smartphones. Viele Keime überleben dort stunden- bis tagelang. Wer sich regelmäßig die Hände wäscht, schützt sich und andere. Wo keine Waschmöglichkeit besteht, ist Desinfektion eine gute Ergänzung.
Auch einfache Verhaltensweisen helfen: Etwa beim Husten oder Niesen die Armbeuge zu nutzen. Auch regelmäßiges Lüften, besonders in geschlossenen Räumen, ist wichtig. Zudem sollte man bei Krankheit lieber zu Hause bleiben und ganz generell das Händeschütteln bewusst einsetzen – in bestimmten Situationen kann ein verbaler Gruß genauso respektvoll und gleichzeitig hygienischer sein.
Infektionsschutz bedeutet nicht Isolation – sondern bewusste Entscheidungen im Alltag. Mit kleinen Gesten Großes bewirken: Für sich selbst und andere.